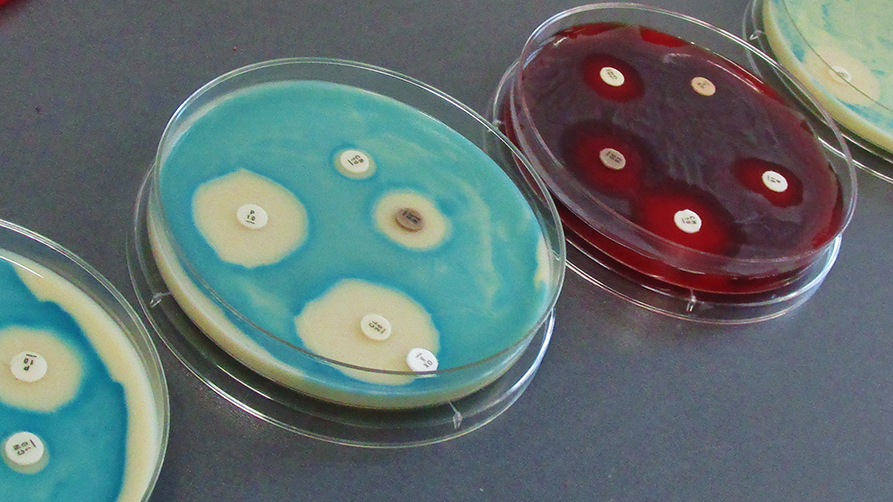

Biozide sind im wörtlichen Sinn ("bios" = griechisch "Leben", "caedere" = lateinisch "töten") Substanzen, die Organismen vernichten. Biozide sind notwendig zur Bekämpfung von Organismen, die für die Gesundheit von Mensch oder Tier schädlich sind. Sie tragen zur Hygiene von Menschen und Tieren bei und werden zur Bekämpfung von Organismen verwendet, die natürliche oder gefertigte Materialien schädigen.
Biozidprodukte sind potenziell auch gefährlich für Menschen, Tiere und die Umwelt und müssen dementsprechend mit der gebotenen Vorsicht gehandhabt werden. Um die notwendige Sicherheit für Verbraucher, Beschäftigte und die Umwelt zu erreichen, dürfen nur zugelassene Biozidprodukte bzw. Produkte, die Übergangsregelungen unterliegen, verwendet werden.
Das Biozid-Portal ist eine Internetseite der am Biozid-Verfahren beteiligten Behörden in Deutschland. Es bietet Informationen über den rechtlichen Rahmen. Sie erhalten hier Hintergrundinformationen zu verkehrsfähigen Biozidwirkstoffen und -produkten. Sie erhalten auch Hinweise, wie Sie als Verbraucher im Alltag Biozidprodukte ersetzen oder die Einsatzmenge reduzieren können. Sie können sich über mögliche Schädlinge informieren und über die Maßnahmen und Produkte, mit denen diese vermieden werden können.
Folgende deutsche Behörden sind am Biozid-Verfahren beteiligt:
Der Fachbereich 5 der Bundesanstalt für Arbeitsschutz und Arbeitsmedizin (BAuA)

Die BAuA ist im Chemikaliengesetz als Bundesstelle für Chemikalien (BfC) benannt.
Die BfC ist nach dem Chemikaliengesetz die zuständige deutsche Behörde zur Umsetzung der Verordnung (EU) Nr. 528/2012 über die Bereitstellung auf dem Markt und die Verwendung von Biozidprodukten (Biozid-Verordnung).
Die BfC arbeitet in diesen Verfahren eng mit den anderen beteiligten Bundesbehörden zusammen, erstellt die deutsche Gesamtposition und vertritt diese nach außen gegenüber der Europäischen Chemikalienagentur (ECHA) und der EU-Kommission. Die BfC bewertet die chemische Identität von Bioziden und z.T. die Wirksamkeit.
Auf der Internetseite der BfC finden Sie:
- Hinweise zum rechtlichen Rahmen des Biozid-Verfahrens
- Hintergrundinformationen zu zugelassenen Biozidprodukten und Wirkstoffen.
Der Fachbereich 4 der Bundesanstalt für Arbeitsschutz und Arbeitsmedizin (BAuA)
Aufgabe des Fachbereichs 4 "Gefahrstoffe und biologische Arbeitsstoffe" ist die Bewertung biozider Wirkstoffe und die Zulassungen von Biozidprodukten unter Arbeitsschutzaspekten. Sie umfasst die Bewertung von Risiken (Exposition, Toxikologie) für berufliche Anwender bei der Handhabung und die Festlegung von Maßnahmen für den sicheren Umgang am Arbeitsplatz.
Im Rahmen dieser Arbeit wurden und werden durch den Fachbereich verschiedene Forschungsprojekte durchgeführt. Untersucht werden dabei die ordnungsgemäße Verwendung, Einhaltung der guten fachlichen Praxis und geeignete Schutzmaßnahmen.
Bundesinstitut für Risikobewertung (BfR)

Das BfR ist als Einvernehmensbehörde zuständig für die gesundheitliche Risikobewertung von Biozidprodukten und deren Wirkstoffen. Nach dem Biozidgesetz wurden dem BfR folgende Aufgaben im Rahmen der Risikobewertung übertragen:
-
Beurteilung unannehmbarer Auswirkungen auf die Gesundheit von Mensch oder Tier unter Berücksichtigung einer Exposition über Trinkwasser, Nahrungs- oder Futtermittel, sowie Luft in Innenräumen, einschließlich der
- Gefahrenabschätzung (toxikologisches Wirkprofil und Dosis-Wirkungsbeziehungen von Stoffen und Produkten mit Ableitung von Grenzwerten).
- Expositionsabschätzung (erwartbare und gegebenenfalls tolerierbare Rückstände besonders im Trinkwasser, in Nahrungs- oder in Futtermitteln sowie in der Luft von Innenräumen)
- Risikocharakterisierung (Abschätzung des gesundheitlichen Risikos für Verbraucher, beispielsweise Verwender von Biozidprodukten, und über die Umwelt exponierte Personengruppen)
- Bewertung von Analysenmethoden für Wirkstoffe und andere toxikologisch signifikante Rückstände für die Überwachung der zugelassenen Verwendung von Biozidprodukten.
-
Beurteilung unannehmbarer Auswirkungen auf Zielorganismen, einschließlich der
- Erzeugung von unannehmbaren Resistenzen oder Kreuzresistenzen und der
- Verursachung vermeidbarer Leiden oder Schmerzen bei Wirbeltieren.
Das Umweltbundesamt (UBA)

Das UBA ist im Chemikaliengesetz als Einvernehmensbehörde im Zulassungsverfahren von Biozidprodukten und im Verfahren zur Prüfung von Biozidwirkstoffen benannt. In dieser Zuständigkeit bewertet das UBA die
- Wirkungen von Bioziden auf die Umwelt unter Berücksichtigung der spezifischen Verwendung und entwickelt Maßnahmen zur Risikominderung und nachhaltigen Minimierung des Biozideinsatzes.
- Darüber hinaus übernimmt das UBA für spezifische Biozidproduktarten (Insektizide/Akarizide, Nagetierbekämpfungsmittel, Repellentien, Trinkwasser- sowie Schwimm-und Badebeckenwasserdesinfektionsmittel) die Bewertung der Wirksamkeit.
Auf der Internetseite des UBA finden Sie Informationen
- über die Wirkungen von Bioziden auf die Umwelt sowie
- zu vorbeugenden und alternativen Maßnahmen zur Minimierung des Biozideinsatzes,
- zu Leitfäden für die Umweltprüfung und Bewertungskonzepte,
- zu Forschungsvorhaben, Fachbeiträgen und
- Hinweise auf wichtige Veranstaltungen zum Thema Biozide.
Bundesanstalt für Materialforschung und -prüfung (BAM)

Die BAM ist als Bewertungsstelle im Vollzug vom Biozidgesetz nach § 12j Absatz 2 Chemikaliengesetz (ChemG) zuständig für die Bewertung der Wirksamkeit von Bioziden im Materialschutz. Darüber hinaus wird im Auftrag der Zulassungsstelle Biozide
- die Dossierbearbeitung zu ausgewählten physikalisch-chemischen Eigenschaften (sicherheitstechnische Kenngrößen), zur Verpackung und zu Emissionen in Verbindung mit Unfallfeuer übernommen, sowie
- die Erstellung von Gesamtberichten und redaktionelle Beteiligung an den Bewertungen für die Zulassungsstelle Biozide in Dortmund, der Europäischen Chemikalienagentur (ECHA) in Helsinki und der EU-Kommission in Brüssel erfüllt.
Die BAM nimmt Aufgaben zur Umweltverträglichkeit gegenüber Bundesregierung und nationalen sowie internationalen Gremien / Unternehmen wahr. Dazu gehören die Bewertung von Stoffen, Gemischen, Erzeugnissen und Verfahren unter Umweltaspekten sowie die Erstellung von Obergutachten und Stellungnahmen zu Studien von Dritten.
Auf der Biozid-Seite der BAM finden Sie insbesondere Hintergrundinformationen zu Fragen des Materialschutzes durch Biozide.